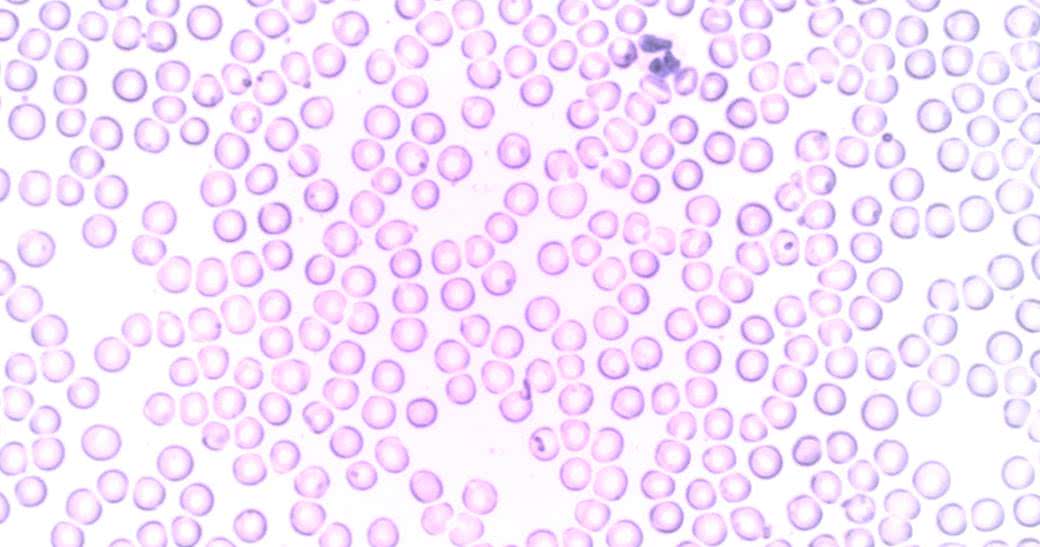

Czym są neutrofile?
Granulocyty obojętnochłonne, a więc neutrofile, to fagocyty. Oznacza to, że są one zdolne do poruszania się w miejsca, gdzie zaatakował patogen. To ważne, ponieważ neutrofile należą do grupy białych krwinek, czyli biorą udział w ochronie organizmu przed patogenami.
Neutrofile są tzw. pierwszą linią obrony, bowiem to za ich sprawą uruchamiane są mechanizmy niszczące wirusy i bakterie. Neutrofile są najliczniejsze wśród leukocytów. Produkowane są w szpiku kostnym i uwalniane do krwi, gdzie krążą w poszukiwaniu patogenów, a następnie ulegają zaprogramowanej śmierci. Ich produkcja trwa nieustannie. W zdrowym organizmie neutrofile utrzymują się na stałym poziomie. Istnieją jednak czynniki, które powodują wahania w ich normach.
Jak działa układ odpornościowy?
Odporność to zdolność organizmu do zwalczania patogenów i ochrony przed drobnoustrojami. Umożliwiają ją komórki odpornościowe (takie jak neutrofile), które przemieszczają się po całym organizmie wraz z krwią i limfą i wykrywają obce komórki (np. takie, które pojawiły się na skutek zakażeń bakteryjnych), a następnie je niszczą. Jest to system niemal doskonały, pozwalający na utrzymanie organizmu w zdrowiu.
Niestety, zdarza się, że układ odpornościowy uznaje własne komórki za wroga. Dochodzi wówczas do chorób autoimmunologicznych (jak toczeń czy choroba Hashimoto) i niszczenia własnych komórek. Zdarza się także, że organizm uznaje za wroga neutralne substancje, jak np. pyłki roślin. W takich wypadkach układ odpornościowy reaguje kaszlem, łzawieniem, dusznościami, katarem ‒ mowa o alergiach.
Ogółem jednak organizm wie, co robi, a to przez cykl nabywania odporności. Nabywanie odporności oznacza, że na skutek kontaktu organizmu z wirusem w układzie immunologicznym pojawiają się przeciwciała. Dzięki temu organizm więcej nie zachoruje na chorobę wywołaną przez danego wirusa.
Za cykl nabywania odporności odpowiadają:
- odporność nabyta (swoista), która wykształca się po kontakcie z drobnoustrojem (komórki wytwarzają pamięć immunologiczną i w przypadku ponownego kontaktu z tym samym drobnoustrojem już wiedzą, jak go zniszczyć),
- szczepienia, które działają na podobnej zasadzie jak odporność swoista, a więc uczą organizm rozpoznawania konkretnego patogenu i inicjowania odpowiedzi odpornościowej.
Neutrofile - normy
Aby oznaczyć poziom neutrofili, należy wykonać badanie morfologiczne. Najlepiej jest je zrobić w godzinach porannych i na czczo, wówczas wynik jest najbardziej miarodajny. W gabinecie laboratoryjnym pobierana jest najczęściej z żyły łokciowej próbka krwi, która następnie przesyłana jest na badanie morfologiczne do laboratorium.
Neutrofile w wyniku badania oznaczone są jako NEU, a ich normy to:
- 1800 - 8000/μl (liczba komórek na mikrolitr badanej krwi) lub
- 60 - 70% (procentowa ilość neutrofili wśród białych krwinek).
Poziom neutrofili ustala się na podstawie całkowitej ilości leukocytów i granulocytów.
Co może wpływać na zmiany poziomu neutrofili?
- zakażenia bakteryjne
- przewlekły stres, znaczący spadek hormonów tarczycy
- ciąża
- palenie papierosów
- reumatoidalne zapalenie stawów
Wszystkie te czynniki mogą zaktywizować układ odpornościowy i sprawić, że wyśle on fagocyty na zwiady. Tym samym neutrofile mogą się gwałtownie namnożyć. Lub odwrotnie: ich liczba może się niespodziewanie obniżyć.
Neutrofile podwyższone - co oznaczają?
Kiedy poziom neutrofili przekracza 8000/μl, dochodzi do neutrofilii, czyli stanu przekraczającego górną granicę poziomu granulocytów obojętnochłonnych.
Przyczyny podwyższonych neutrofili
- zakażenia bakteryjne
- infekcja grzybicza
- nadczynność kory nadnerczy
- dna moczanowa
- reumatoidalne zapalenie stawów
- nadmiar kortykosteroidów
- znacząca utrata krwi
- białaczka szpikowa
- cukrzycowa kwasica ketonowa
- wysoki poziom stresu lub duży wysiłek fizyczny
Kiedy badanie morfologii wskaże, że neutrofile znajdują się na zbyt wysokim poziomie, należy zgłosić się do lekarza, który pomoże ustalić przyczynę takiego stanu rzeczy i wskaże odpowiednią drogę postępowania.
Za niskie neutrofile - co to znaczy?
Neutrofile są za niskie, gdy ich poziom spada poniżej 1800 μl. Gdy ich poziom spadnie poniżej 1500 μl, mówimy o neutropenii. Najczęstszą przyczyną neutropenii jest chemio- lub radioterapia. Ale przyczyn tego, że neutrofile są za niskie, może być więcej.
Przyczyny obniżonych neutrofili
- nadczynność tarczycy
- choroby autoimmunologiczne
- zakaźne choroby wątroby
- salmonella
- włóknienie szpiku kostnego
- zakażenia wirusowe
- przyjmowanie niektórych leków, np. antybiotyków lub leków diuretycznych
- niedobory witamin
- nadmierne spożywanie alkoholu
- zespół niedoboru odporności
Co zrobić, gdy mamy za niskie neutrofile? W przypadku neutropenii powinno się postępować tak samo jak w przypadku neutrofilii: należy zgłosić się do lekarza i ustalić sposób leczenia.
Jaka jest norma neutrofili u dziecka?
Neutrofile w przypadku dzieci są aktywizowane o wiele częściej niż w przypadku osób dorosłych. Organizm dziecka dopiero uczy się odporności, poznaje wirusy, bakterie i drobnoustroje – dlatego neutrofile u dziecka mogą być poniżej lub powyżej normy. Np. za niski poziom neutrofili może świadczyć o przebytej infekcji wirusowej, z kolei za wysoki poziom neutrofili może oznaczać stan zapalny w organizmie lub wysiłek fizyczny.
Normę neutrofili u dziecka oblicza się na podstawie stosunku wartości wszystkich krwinek białych, co pozwala określić bezwzględną wartość stężenia neutrofili we krwi. Rzecz jasna, nie należy oceniać tego samodzielnie i warto zasięgnąć porady lekarza – zwłaszcza w przypadku dziecka.
- British Society for Immunology, Eberl M., Davey M., Neutrophils, immunology.org, https://www.immunology.org/public-information/bitesized-immunology/cells/neutrophils/.
- Encyclopedia Britannica, Neutrophil leukocyte, britannica.com, https://www.britannica.com/science/neutrophil.
- Grossesblutbild.de Medizinwissen, Harald S., Neutrophile Granulozyten Werte zu hoch, grossesblutbild.de, https://www.grossesblutbild.de/neutrophile-granulozyten-werte.html.
- Healthline, York Morris S., Sampson S., Understanding Neutrophils: Function, Counts, and More, healthline.com, https://www.healthline.com/health/neutrophils.
- Medical News Today, Huizen J., Sampson S., What are neutrophils and what do they do?, medicalnewstoday.com, https://www.medicalnewstoday.com/articles/323982.
- Msd Manual Ausgabe für Patienten, Territo M., Neutrophile Leukozytose, msdmanuals.com, https://www.msdmanuals.com/de-de/heim/bluterkrankungen/st%C3%B6rungen-der-wei%C3%9Fen-blutk%C3%B6rperchen/neutrophile-leukozytose.
- National Cancer Institute, Neutrophil, cancer.gov, https://www.cancer.gov/publications/dictionaries/cancer-terms/def/neutrophil.
- National Center for Biotechnology Information, U.S. National Library of Medicine, Uribe-Querol E., Rosales C., Neutrophils in Cancer: Two Sides of the Same Coin, ncbi.nlm.nih.gov, https://www.ncbi.nlm.nih.gov/pmc/articles/PMC4706937/.
- NetDoktor, Machetanz L., Rudolf-Müller E., Neutrophile Granulozyten, netdoktor.de, https://www.netdoktor.de/laborwerte/neutrophile-granulozyten/.
- VerywellHealth, Eldridge L., Neutrophils Function and Abnormal Results, verywellhealth.com, https://www.verywellhealth.com/what-are-neutrophils-p2-2249134.

 Nasze magazyny
Nasze magazyny